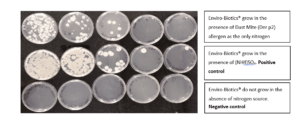

Les allergènes, qui sont principalement des matières organiques sous forme de protéines et de toxines de moisissure, générées par les acariens, les animaux de compagnie, le pollen et d’autres sources, sont la cause de troubles respiratoires des allergies, y compris l’asthme. Découvrez comment les Enviro-Biotics® consomme ces allergènes et crée une zone sûre pour ceux qui souffrent d’allergies.
Le rythme accéléré de l’augmentation des maladies allergiques est en corrélation avec l’augmentation du temps passé à l’intérieur, où nous passons plus de 90% de notre temps, nos extractions à l’intérieur sont contaminées par de nombreux allergènes . Ces allergènes provoquent malaises, maux de tête, fatigue et dans sa forme plus grave – l’asthme et même les maladies cardiaques.
La réduction des allergènes est réalisée par une nouvelle technologie qui exploite la nature:
Les cellules de Bacillus sont connues pour leur taux de sécrétion élevé des enzymes protéolytiques qui dégradent facilement les protéines adjacentes vers leur consommation par les cellules comme des nutriments précieux.
Étant donné que tous les déterminants antigéniques (les épitopes qui stimulent les réactions allergiques) sont composés de protéines, l’exposition des allergènes aux enzymes protéolytiques, les neutralise et les rend inoffensives.
Cette propriété préventive de l’inactivation des allergènes par les cellules bactériennes des Enviro-Biotics a été contestée à plusieurs reprises; Ce qui suit représente les 3 principales études les plus récentes exécutées par le Dr Sivasankar Baalasubramanian, directrice exécutive de Indoor Biotechnologies Inc. basée à Cardiff, Royaume-Uni avec des laboratoires supplémentaires à Charlottesville, Virginie, États-Unis et Bangalore Inde.
Figure 1: Croissance des Enviro-Biotics® en présence d’allergènes acariens (Der P2) seuls par rapport à une source d’azote (NH4) SO4
Inférence : les bactéries Bai montrent une croissance en présence d’allergène comme seule source d’azote.
L’étude a confirmé que les allergènes sont des aliments pour nos souches de Bacillus et la consommation des allergènes les plus courantes a été mesurée et reportée:
Vous trouverez ci-dessous un échantillon des résultats de l’étude où les acariens de poussière (l’une des principales cause d’asthme) ont été mesurées et en dessous des allergènes des animaux avec des résultats similaires

Ces résultats sont corroborés par le laboratoire EMSL américain
Comme indiqué dans le rapport de l’EMSL, l’application des Enviro-Biotics en suspension dans une salle familiale diminue la présence de l’allergène de la poussière (der F1) par x20.
Le succès de la réduction d’une variété d’agents pathogènes et d’allergènes sur un large spectre a été rendu possible en raison du fait que les Enviro-Biotics sont une formule multi-souches, où chaque déformation est un contrôle fonctionnel d’un groupe d’allergènes communs, lorsqu’il est activé de manière concurrentielle, Créer une protection très efficace de l’intérieur contre toutes sortes d’allergènes.